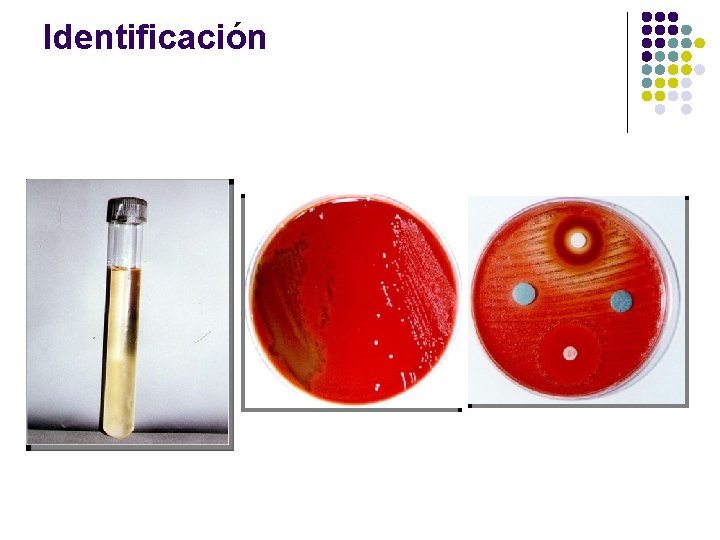
Identificación

Bacterias Anaerobias Esporuladas y no Esporuladas Microbiologa Clnica

Bacterias Anaerobias Esporuladas y no Esporuladas Microbiología Clínica Prof. Dr. Marcos Colmán Isasi 2015

Objetivo Conocer las principales características biológicas de los gérmenes anaerobios esporulados y no esporulados, su capacidad para producir infecciones, las posibilidades diagnósticas y las medidas profilácticas

Anaerobios No Esporulados Características generales l Son incapaces de desarrollar en contacto con el oxígeno l Anaerobios estrictos: requieren un 0% de oxígeno para crecer l Anaerobios aerotolerantes: sobreviven hasta con 0, 5% de oxígeno l Son exigentes para crecer, necesitan vitaminas y cofactores. l Forman parte de la flora normal del hombre y de los animales. l Producen infecciones oportunistas, generalmente endógenas. l Las infecciones generalmente son mixtas con bacterias aerobias. l Incluyen a varios géneros de cocos y bacilos, grampositivos y gramnegativos.

Bacterias Anaerobias Efecto tóxico del oxígeno • Efecto tóxico directo • Formación de anión peróxido y superóxido • Oxidación de enzimas esenciales que contengan grupos SH • Inhibición del metabolismo de flavoproteínas y NADH oxidasa • Imposibilidad para alcanzar potenciales redox bajos • Déficit o ausencia de catalasa y/o superóxido dismutasa (presente en aerotolerantes)

Factores de virulencia de bacterias anaerobias l l l Adherencia a las células Polisacárido capsular Endotoxina Hialuronidasa, colagenasa, fibrinolisina, neuraminidasa Exotoxinas

Flora Normal Anaerobia • Piel: la flora normal se limita a los folículos pilosos. • Boca y faringe: flora muy abundante. Las encías son un nicho muy importante. Se asocian con infecciones a nivel de cabeza y cuello. • Intestinos: hay 1. 000 veces más anaerobios que aerobios. Degradan sales biliares, sintetizan vitaminas y se oponen a la colonización por otras bacterias. Se relacionan con infecciones abdominales. • Vagina: Predominan los Lactobacillus en condiciones normales. Alteraciones hormonales y tratamientos con antibióticos alteran la flora con sobrecrecimiento de otras bacterias (vaginosis). Se asocian con aborto séptico.

Flora normal anaerobia Cavidad oral y TRS: Piel: Propionibacterium acnes Peptostreptococcus Bacilos gram-negativos: Porphyromonas Prevotella, Fusobaterium nucleatum – Cocos gram-positivos Actinomyces 100: 1 (ANA/AER) Tracto genital femenino: Bacilos gram-negativos: Porphyromonas Prevotella bivia-disiens Cocos gram-positivos Lactobacillus Clostridium Colon Bacilos gram-negativos: Bacteroides grupo fragilis – Cocos gram-positivos - Clostridium, Eubacterium, Bifidobacterium 1000: 1 (ANA/AER)

Cocos Gramnegativos Anaerobios Género Veillonella V. parvula

Cocos Grampositivos Anaerobios Género Peptostreptococcus P. anaerobius P. magnus P. micros P. asaccharolyticus

Bacilos Grampositivos Anaerobios Género Actinomyces A. israelii A. odontolyticus A. viscosus Género Eubacterium E. lentum E. aerofaciens Género Lactobacillus L. cassei L. bulgaricus L. yoghurtii

Bacilos Grampositivos Anaerobios Género Propionibacterium P. acnes P. propionicum P. granulosum P. avidum Género Bifidobacterium B. dansium Género Mobiluncus M. curtisii M. mullieris

Bacilos Gramnegativos Anaerobios Género Bacteroides B. fragilis B. thetaiotaomicron Género Porphyromonas P. gingivalis P. endodontalis Género Prevotella P. melaninogenica P. bivia Género Fusobacterium F. nucleatum F. necrophorum

Características de las infecciones por Anaerobios ENDOGENAS • Polimicrobianas • Relacionadas a mucosas • Sinérgicas

Características de las infecciones por Anaerobios EXOGENAS • Clostridiales • No Clostridiales

Infecciones por anaerobios: q Odontógenas – Cabeza y cuello q Abdominales q Piel y partes blandas q Ginecológicas: vaginosis, abscesos vaginales, aborto séptico, etc q SNC: abscesos cerebrales, empiema subdural q Oseas

Infección por anaerobios: Factores predisponentes: q. Enfermedades vasculares q. Cuerpos extraños q. Shock q Enfermedades malignas q. Traumatismos q Edema q. Cirugías q Infecciones previas

Infecciones por anaerobios Características • Olor pútrido de las secreciones purulentas • Proximidad a mucosas • Gas en el sitio de la infección • Necrosis tisular o gangrena • Tratamiento previo con aminoglucósidos (inactivos frente a anaerobios) • Infección secundaria a mordeduras animales o humanas • Paciente portadora de Dispositivo Intrauterino • Maniobras comprometedoras (cirugía abdominal o aborto provocado) • Evolución lenta de la enfermedad • Coloración negra de la herida • Gránulos de azufre (actinomycosis) • No desarrollo en aerobiosis de los microorganismos observados en el Gram.

Infecciones por anaerobios l l Son polimicrobianas y endógenas, por lo tanto su etiología puede ser predecible de acuerdo a la localización. El hallazgo de un patógeno determinado permite sospechar cual es el foco de infección Las características de la muestra nos permiten sospecharlos. Tratamiento basado en: debridamiento, drenaje y ATB

Infecciones por anaerobios Prevención • Uso racional de los antimicrobianos • Tratamiento de las enfermedades de base • Minimizar el uso de técnicas invasivas • Disminuir el tiempo de internación • Tratar rápidamente las heridas profundas, especialmente las punzantes o secundarias a mordeduras humanas y de animales

Recolección, transporte y conservación de muestras

Muestras NO aptas para cultivo anaerobios l l Heces o materiales que estén contaminados contenido intestinal (excepción C. difficile) Exudados vaginales o cervicales Orinas tomadas por micción espontánea o sonda Esputos, secreciones nasofaringeas o materiales tomados por broncoscopía sin protección.

Muestras aptas para cultivo anaerobios l l Líquidos normalmente estériles: LCR, pleural, peritoneal, etc. Muestras tomadas por punción a través de piel sana (Heridas, hematomas, colecciones, punción suprapúbica, etc. ) Muestras de endometrio, pulmón, etc. , tomadas por biopsia o cepillos recubiertos. Biopsias (de sitios sin flora habitual)

Transporte y conservación de muestras l l l Las muestras líquidas, purulentas y de volumen considerable pueden transportarse en tubos estériles. Las colecciones claras o de volúmenes reducidos pueden inyectarse en frasquitos con tapón de goma y atmósfera inerte, sin introducir aire. No es conveniente el sistema de transporte de muestras en jeringas, porque permite la difusión del oxígeno al interior de la muestra. Los raspados, hisopados y piezas de tejido pequeñas pueden colocarse en tubos que contengan medio de Stuart, Cary-Blair, pre-reducido. Las piezas de tejido con un volumen mayor a 1 cm 3, pueden transportarse en recipientes estériles, sin conservantes.

Transporte de Muestras • Frascos para hemocultivos anaeróbicos • Jeringa y aguja con tapón de goma (No se aconseja por cuestiones de bioseguridad) • Frascos con medios prerreducidos

Tiempo de transporte sugerido según: volumen, método de conservación y tipo de muestra Muestra Tiempos hasta la siembra Aspirados < 1 ml 1 -2 ml > 2 ml Tejidos y biopsias - +) en recipiente estéril sin anaerobiosis - +) en bolsa anaeróbica 10 minutos 30 minutos 2 – 3 horas 30 minutos 2 - 3 horas

Conclusiones l l Obtener las muestras en forma adecuada Protegerlas de los efectos deletéreos del oxígeno Mantenerlas a temperatura ambiente Las mejores muestras son las obtenidas de cavidades cerradas a través de tejidos no contaminados

Bacterias anaerobias: Diagnóstico microbiológico e identificación

Cultivo de anaerobios: Muestra l Características macroscópicas: aspecto, olor, fluorescencia, etc Observación microscópica: flora polimicrobiana, leucocitos, orienta terapia empírica, etc. l

Gérmenes Anaerobios - Diagnóstico Sospecha clínica Toma de Muestra Coloración de Gram Siembra en Agar sangre con y sin ATB Incubar 48 hs a 37ºC en anaerobiosis Morfología colonial y Gram Pruebas bioquímicas

Diagnóstico microbiológico: Cultivo l Utilizar medios frescos, recientemente preparados o pre-reducidos l Procesar rápidamente l Evaluar qué microorganismos buscamos para elegir el medio: suplementos específicos

Diagnóstico microbiológico: Medios l Medios sólidos NO selectivos: (Agar base enriquecido: Brucella, Columbia, Schaedler, etc) l l Medios sólidos selectivos: l l l Agar Base + Vit K (1 mg/ml) + Hemina (5 mg/ml) + sangre lacada al 5% (BHKA) BHKA + KAN (30 a 50 µg/ml) BHKA + VAN (5 µg/ml) Medios líquidos: Resguardo (“Backup”) l Caldo BHI, tioglicolato suplementado con cisteína, Vit K y hemina.

Cultivo de anaerobios: Atmósfera l Métodos para generar atmósfera anaerobia: l l Mezcla de gases: Se utiliza una mezcla compuesta por 5 -10% H 2, 5 -10% CO 2 y 80 a 90% de N 2, Generadores comerciales: Hay diferentes sistemas comerciales: l Con catalizador (Gas Pack, BBL; Anaerobic Gas generator, Oxoid): BH 4 Na y ácido cítrico y una tableta de HCO 3 Na para generar H 2 y CO 2 l Sin catalizador: mezcla de reactivos que fijan el O 2 y generan CO 2. ** Activados con agua: Anaerocult, Merck; Britania. ** Activan al contacto con el aire: Anaerogen, Oxoid; Key Scientific, Mitsubishi; Genbox, Biomerieux

Cultivo de anaerobios: Atmósfera l Sistemas de incubación: a) Jarras anaerobias b) Cámara anaerobia c) Bolsas anaerobias

Obtención de atmósfera anaerobia

Obtención de atmósfera anaerobia Cámara Anaerobia

Cultivo de anaerobios: Incubación - Controles l Incubación: l l l al menos 48 hs a 35 -37ºC, hasta 5 a 7 días. Atmósfera anaerobia (< 1% O 2) Control de anaerobiosis Indicadores de Ox-Red: resarzurina, azul de metileno l Recuperación de anaerobios estrictos: F. nucleatum, BGN pigmentados, etc. l

Bacterias anaerobias Identificación

Identificación de Anaerobios: Limitaciones técnica l l Bacterias fastidiosas Requerimientos culturales especiales l l Atmosfera (<1% O 2) Nutrientes Tiempo de desarrollo Metabolismo (algunos inactivos)

CULTIVO DE ANAEROBIOS: Identificación Procedimiento a seguir con cada colonia: Prueba de tolerancia al oxígeno (CA) (en agar chocolate en Lata con vela) Colonia Descripción macroscópica Coloración de Gram

IDENTIFICACION PRESUNTIVA Gram 1 - Bacilos gram negativos: 2 - Bacilos gram positivos: Discos potencia especial : Vc 5µg+ Cs 10µg + Ka 1000 µg No esporulados: Esporulados: Indol Catalasa Glucosa CAMP reversa Bilis Nitrato Gelatina Urea Indol Lipasa Lecitinasa Nitrato Indol Esculina Catalasa 4 - Cocos gram positivos: 3 - Cocos gram SPS Indol negativos: Nitrato Fluorescencia (UV) Tablas Específicas Nitrato Esculina Catalasa Urea
Identificación

IDENTIFICACION: CONCLUSIONES § § Buena observación micro y macroscópica Siempre hacer pruebas básicas de entrada Utilizar pruebas rápidas en spot o enzimas preformadas (inóculo alto) Asegurarse buen desarrollo en pruebas de crecimiento.

Anaerobios Esporulados

Características generales l Son incapaces de desarrollar en contacto con el oxígeno l Resisten hasta 120ºC, la desecación y cambios de p. H l Forman parte de la flora normal del hombre y de los animales. l Se los encuentra ampliamente distribuidos en el agua, el suelo y las plantas l Producen infecciones oportunistas. l Su acción se manifiesta por la producción de potentes exotoxinas. l Incluyen al género Clostridium con varias especies. l Las infecciones son muy típicas y el diagnóstico generalmente es clínico.

Anaerobios Esporulados Clasificación l l l Neurotóxicos l Clostridium tetani l Clostridium botulinum Histotóxicos l Clostridium perfringens l Clostridium septicum Enterotóxicos l Clostridium difficile l Clostridium perfringens

Clostridium tetani

Clostridium tetani l Se encuentran en el suelo e intestino del hombre y animales. l Las esporas ingresan a través de heridas. l Al alcanzarse el potencial redox adecuado la espora germina. l La forma vegetativa produce una exotoxina (tetanoespasmina). l La toxina difunde por vía neural hasta las neuronas motoras. l En SNC bloquea la liberación de glicina y GABA. A nivel periférico inhibe la liberación de acetilcolinesterasa dando como resultado la estimulación incontrolada de los músculos esqueléticos. l El paciente muere por parálisis de los músculos respiratorios.

Clostridium tetani

Clostridium tetani - Prevención l Se previene vacunando con el toxoide tetánico (Vacuna DPT o antitetánica sola). l Se aplica a los 2, 4 y 6 meses. Primer refuerzo a los 18 meses y segundo refuerzo al ingreso escolar. Cada 10 años deben aplicarse refuerzos. La embarazada debe vacunarse al 5 to y 7 mo mes de embarazo. l Deben lavarse perfectamente las heridas profundas, principalmente las producidas por material herrumbrado y las contaminadas con tierra o materia fecal. l En caso de heridas puede emplearse profilácticamente la antitoxina, la cual se administra en forma conjunta con la vacuna.

Clostridium botulinum

Clostridium botulinum l Se encuentran en la tierra y sedimentos acuáticos l La fuente más común de intoxicación es la ingestión de conservas o fiambres caseros. l Al alcanzarse el potencial redox adecuado la espora germina en el alimento y la forma vegetativa produce una exotoxina. l La toxina ingresa por vía digestiva y difunde por vía humoral hasta las neuronas motoras. l La toxina bloquea la liberación de acetilcolina dando como resultado una parálisis fláccida de los músculos esqueléticos. l El paciente muere por parálisis de los músculos respiratorios.

Clostridium botulinum

Clostridium botulinum - Prevención l Deben cumplirse estrictamente las normas de seguridad en la manipulación de los alimentos en la industria alimentaria. l Debe educarse a la población general respecto de los procedimientos seguros de envasado de los alimentos. l En caso de dudar del origen de los alimentos, deben calentarse 10 minutos a 100ºC para destruir la toxina. l No debe administrarse miel a lactantes menores de 1 año de edad (Botulismo del lactante). l No existe vacuna de aplicación universal.

Aplicaciones de la Toxina botulínica tipo A: Botox Indicaciones terapeúticas l l l Espasticidad asociada con accidente cerebro vascular. Tratamiento en pacientes con parálisis cerebral Distonía cervical (tortícolis) en adultos Blefarospasmo y espasmo hemifacial Corrección del estrabismo Tratamiento focalizado de la hiperhidrosis axilar.

Aplicaciones de la Toxina botulínica tipo A: Botox Indicación cosmética Corrección estética facial para remoción de arrugas glabelares.

Clostridium perfringens

Clostridium perfringens l Se encuentran en el suelo e intestino del hombre y animales. l La bacteria ingresa a través de heridas en forma endógena o exógena. l Al alcanzarse el potencial redox adecuado la espora germina. l La forma vegetativa produce varias exotoxinas l Las toxinas difunden por contigüidad produciendo necrosis tisular y abundante cantidad de gas. l La infección se manifiesta como gangrena gaseosa cuando afecta al tejido subcutáneo o como mionecrosis cuando afecta al tejido muscular l Con frecuencia debe amputarse el miembro afectado.

Clostridium perfringens

Clostridium perfringens

Clostridium perfringens - Prevención l No existe vacuna de aplicación universal. l Deben extremarse las medidas de asepsia durante las cirugías abdominales o al aplicar inyecciones intramusculares profundas. l Deben tratarse rápidamente con antibióticos las heridas contaminadas. l Cámaras hiperbáricas.

GRACIAS POR LA ATENCIÓN PREGUNTAS? ? ?
- Slides: 61